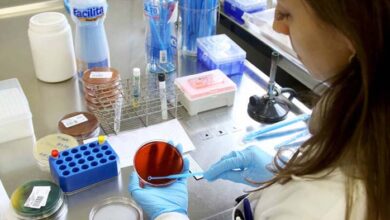

pandemia
-
Local

Pessoas com 50 anos ou mais já podem receber a quarta dose da vacina contra covid em Franca
A Secretaria de Saúde de Franca iniciou nesta segunda-feira, 6, a aplicação da 4ª dose da vacina contra a Covid-19…
Leia mais » -
Local

Em uma semana covid mata mais 4 francanos; número de novos casos quase triplicam
Desde o início da contagem de óbitos em decorrência à complicações causadas pelo coronavírus Franca já contabilizou 1182 perdas. #covid…
Leia mais » -
Local

Sem mortes há 24 dias e com casos graves em queda, Santa Casa fecha leitos covid19
A Santa Casa de Franca encerrou nessa quinta-feira, 7, a ala covid-19 do Hospital do Coração. A informação segue a…
Leia mais » -
Local

Confira a programação da Vacinação contra a covid-19 para terça-feira, 5
A programação da Campanha de Imunização contra a covid-19 para esta terça-feira, 5, terá disponível 12 postos de vacinação, com horário…
Leia mais » -
Local

Franca fura a fila e antecipa 4ª dose para idosos com mais de 80 anos
Numa espécie de corrida por “reconhecimento”, a prefeitura de Franca resolveu furar a fila e antecipar a 4ª dose da…
Leia mais » -
Local

Pronto-Socorro ‘Dr Álvaro Azzuz’ volta a atender casos clínicos e gerais
O prefeito Alexandre Ferreira (MDB) anunciou em suas redes sociais o retorno dos atendimentos clínicos e gerais de urgência Pronto-Socorro…
Leia mais » -
Brasil & Mundo

SP libera uso de máscara em ambientes abertos a partir desta quarta, 9
CARLOS PETROCILO A partir desta quarta (9), o uso de máscara não será mais obrigatório em espaços abertos no estado…
Leia mais » -
Local

Franca fecha fevereiro com 71 mortes por covid-19, quase o dobro de janeiro
O surgimento da nova variante Ômicron e o relaxamento nas restrições de mobilidade, aliado à falta do esquema vacinal completo…
Leia mais » -
Especiais
USP, Unesp e Unicamp formam 25% menos mestres e doutores na pandemia
ISABELA PALHARES O número de titulações de mestrado e doutorado nas três universidades estaduais paulistas caiu 25% durante a pandemia.…
Leia mais » -
Região

Asilo de Paraíso tem surto de covid-19 e mais de 20 idosos são isolados
Segundo a direção do local, todos passam bem, são assintomáticos e estão em uma ala especial. Duas equipes foram contratadas…
Leia mais »






